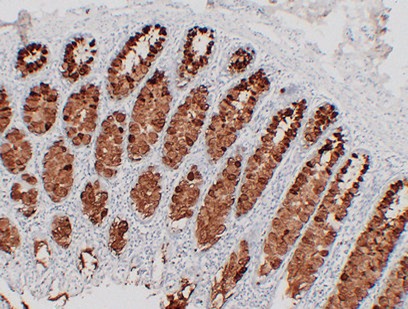

购物车
 您的购物车当前为空
您的购物车当前为空
Anti-MUC2 (ABT-MUC2) Antibody (6O821) 是一种 Mouse 抗体,靶向 MUC2 (ABT-MUC2)。Anti-MUC2 (ABT-MUC2) Antibody (6O821) 可用于 IF,IHC-P。
别名 MUC 2
Anti-MUC2 (ABT-MUC2) Antibody (6O821) 是一种 Mouse 抗体,靶向 MUC2 (ABT-MUC2)。Anti-MUC2 (ABT-MUC2) Antibody (6O821) 可用于 IF,IHC-P。
| 规格 | 价格 | 库存 | 数量 |
|---|---|---|---|
| 50 μL | ¥ 1,330 | 5日内发货 | |
| 100 μL | ¥ 2,195 | 5日内发货 |
TargetMol的所有产品仅用作科学研究或药证申报,不能被用于人体,我们不向个人提供产品和服务。请您遵守承诺用途,不得违反法律法规规定用于任何其他用途。
| 产品描述 | Anti-MUC2 (ABT-MUC2) Antibody (6O821) is a Mouse antibody targeting MUC2 (ABT-MUC2). Anti-MUC2 (ABT-MUC2) Antibody (6O821) can be used in IF,IHC-P. |
| 别名 | MUC 2 |
| 克隆号 | 6O821 |
| 反应种属 | Human |
| 验证活性 | 1. Immunohistochemical analysis of paraffin-embedded Colon. |
| 应用 | IFIHC-P |
| 推荐剂量 | IHC-P: 1:100-500 |
| 抗体种类 | Monoclonal |
| 宿主来源 | Mouse |
| 构建方式 | Hybridoma Monoclonal Antibody |
| 性状 | Liquid |
| 缓冲液 | Liquid in PBS containing 50% glycerol, 0.5% BSA and 0.02% sodium azide. |
| 偶联 | Unconjugated |
| 免疫原 | A synthesized peptide: human MUC2 |
| 抗原种属 | Human |
| 储存方式 | Store at -20°C or -80°C for 12 months. Avoid repeated freeze-thaw cycles. |
| 运输方式 | Shipping with blue ice. |